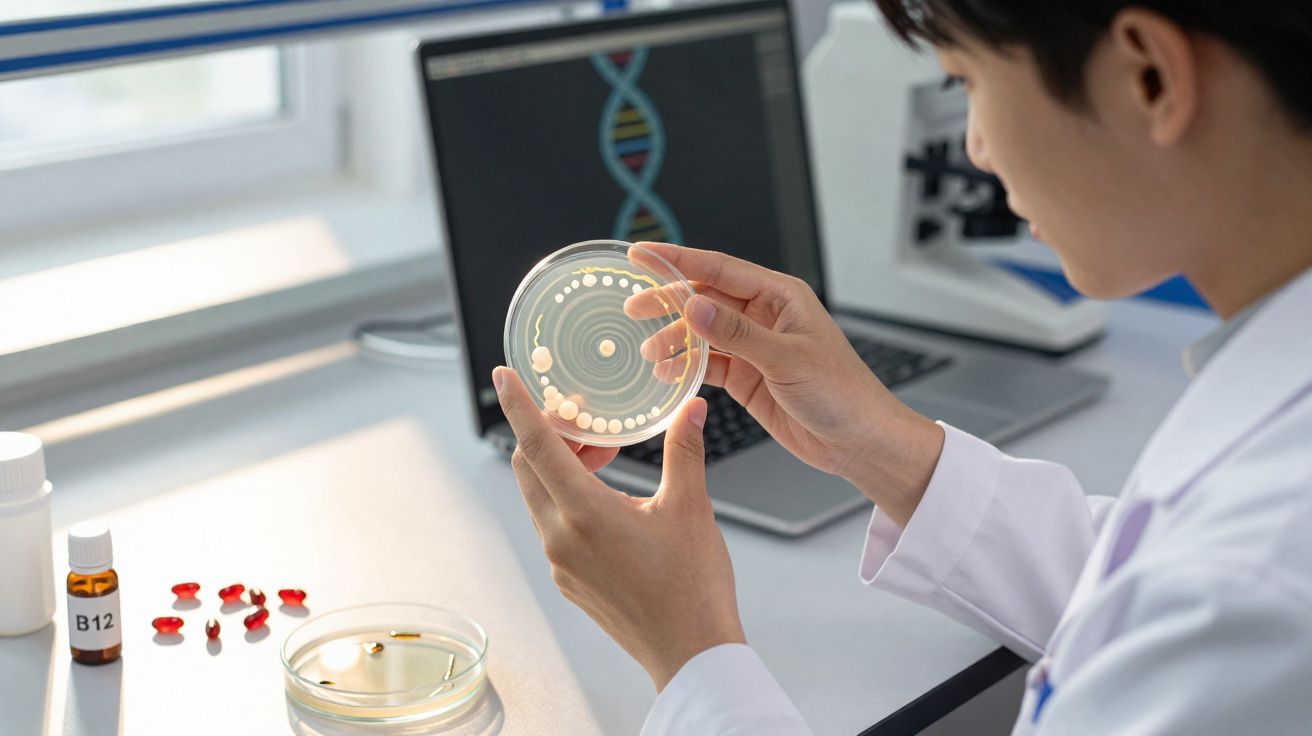
Cientista em laboratório a observar colónias de bactérias numa placa de Petri com DNA no ecrã ao fundo.

Transporta todos os dias, no seu próprio corpo, 100 000 mil milhões de pequenas baterias. Não admira que isto esteja a despertar ideias arrojadas entre engenheiros informáticos e outros investigadores em IA.
A 12 de dezembro de 2025, a revista PNAS Nexus divulgou um resultado particularmente “eléctrico”. Nele, uma equipa da Universidade de Houston e da Universidade Rutgers (Estados Unidos) analisou de perto a forma como funcionam as células do nosso organismo, com especial foco nas membranas lipídicas que as envolvem. Estas membranas actuam como uma capa protectora: ajudam as células a manterem a sua integridade perante agressões externas (como agentes patogénicos), filtram sinais e informação molecular recebida pelo organismo e ainda regulam as trocas metabólicas.
E há mais: essas mesmas membranas podem converter as suas próprias ondulações naturais em electricidade, à semelhança de um gerador. Trata-se de uma fonte de energia até agora desconhecida, mas que, no futuro, poderá apoiar a criação de dispositivos electrónicos bio-inspirados.
Flexoeletricidade nas membranas lipídicas: o movimento convertido em tensão
O mecanismo por detrás desta energia chama-se flexoeletricidade - um fenómeno físico em que a electricidade surge a partir de uma deformação geométrica. Para visualizar, pense na membrana de uma célula como uma folha A4: se a torcer e curvar de forma brusca, cria-se uma separação de cargas eléctricas entre a parte interna e externa da curvatura.
À escala celular, isto não é um evento pontual: é contínuo. As membranas estão sujeitas a ondulação permanente devido ao calor e à actividade de proteínas que as atravessam. Ao deformarem-se milhares de vezes por segundo, comportam-se, assim, como nanogeradores electromecânicos. Os autores do estudo explicam: «Demonstramos aqui que estas flutuações activas, quando acopladas à propriedade universal da flexoeletricidade, podem gerar tensões transmembranares e até orientar o transporte de iões».
Deste modo, as células - através das suas membranas - conseguem recolher a energia de que necessitam para sustentar a sua actividade biológica. De acordo com os cálculos da equipa, estas micro-ondulações poderão produzir uma diferença de potencial até 90 mV (milivolts). À escala de uma tomada doméstica, este valor pode parecer insignificante (cerca de 2 500 vezes inferior), mas, para o universo celular, é enorme: chega para desencadear o impulso nervoso de um neurónio ou comandar a contracção de uma fibra muscular.
Uma nova fonte de inspiração para a IA e a tecnologia
Esta descoberta é, inevitavelmente, apelativa para profissões e áreas que têm a tecnologia como ponto comum. A colheita de energia realizada pelas células pode, um dia, ser aproveitada na produção de uma nova geração de materiais inteligentes e de soluções biomiméticas. Um exemplo seria criar redes de inteligência artificial mais eficientes do ponto de vista energético (um dos seus principais problemas actuais), substituindo transístores de circuitos por nanogeradores bio-inspirados capazes de se auto-alimentarem a partir das vibrações do ambiente.
Em teoria, trata-se de uma via que poderia vir a aplicar-se também aos processadores, que exigem grandes quantidades de energia para tratar informação. Seria o oposto do que fazem as nossas células, que conseguem lidar com tarefas complexas, em parte, reciclando a flutuação das suas membranas. Nas palavras dos autores: «A investigação das dinâmicas electromecânicas nas redes de neurónios pode lançar uma ponte entre a flexoeletricidade molecular e o processamento complexo de informação».
Ainda assim, é importante manter os pés assentes na terra: recorrer à flexoeletricidade como fonte de alimentação, mesmo para um micro-sistema eléctrico, ainda não está ao nosso alcance. Por enquanto, falamos apenas de um modelo teórico, que terá de ser testado in vivo para se perceber se é realmente válido. Isso não retira valor ao trabalho, até porque é o primeiro a demonstrar que as nossas células dependem tanto da química orgânica como da mecânica para gerar o seu fluxo de energia. Talvez um dia existam smartphones ou relógios alimentados por «baterias biológicas», mas muita água ainda terá de correr debaixo das pontes até que isso aconteça.

Comentários
Ainda não há comentários. Seja o primeiro!
Deixar um comentário